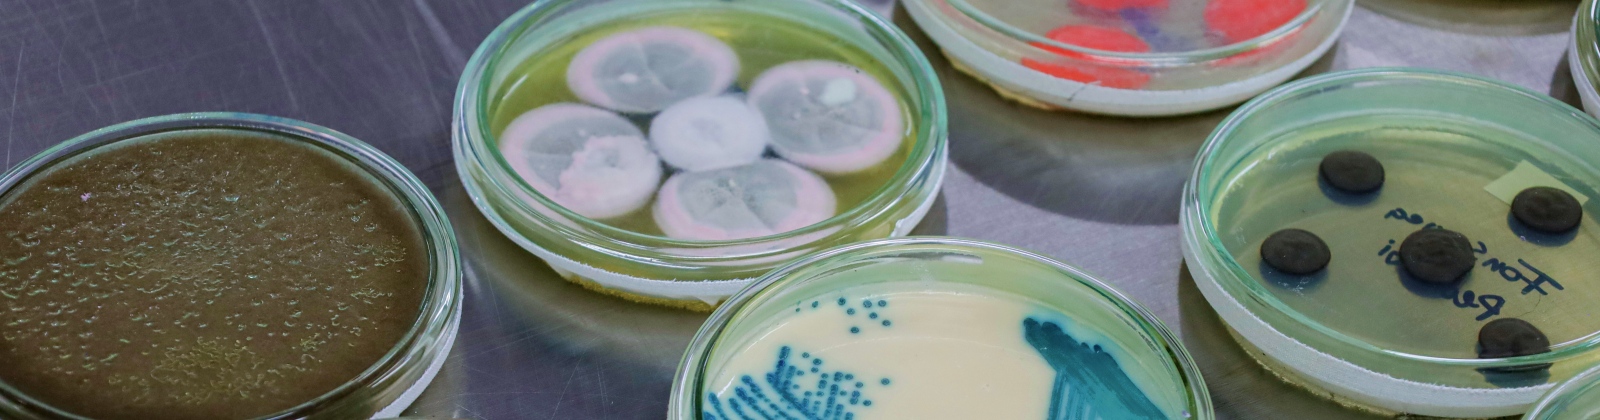
Colección de Microorganismos

Portal U de A - Cabezote - WCV(JSR 286)
Portal U de A - Cabezote - WCV(JSR 286)
 Index Signpost
Index Signpost
Colecciones Biológicas Universidad de Antioquia
 Portal U de A - Visor de Contenido - WCV(JSR 286)
Portal U de A - Visor de Contenido - WCV(JSR 286)
 UdeA - Rotador Interno (Home2) - WCV(JSR 286)
UdeA - Rotador Interno (Home2) - WCV(JSR 286)
 Portal U de A - Visor de Contenido - WCV(JSR 286)
Portal U de A - Visor de Contenido - WCV(JSR 286)
 Footer - Udea - JSR(286)
Footer - Udea - JSR(286)
 Portal U de A - Visor de Contenido - WCV(JSR 286)
Portal U de A - Visor de Contenido - WCV(JSR 286)
La Universidad de Antioquia, reconocida como un centro de excelencia en los estudios sobre biodiversidad, alberga diversas colecciones biológicas que constituyen un valioso componente del patrimonio natural y científico de Colombia. Estas colecciones, cuidadosamente conservadas y permanentemente enriquecidas, fortalecen de manera integral los tres ejes misionales de la Universidad: Docencia, Investigación y Extensión.
A través de ellas, estudiantes, profesores, investigadores y la comunidad en general acceden a una fuente de conocimiento única que facilita la comprensión de la extraordinaria diversidad biológica del país. Las colecciones no solo apoyan la formación académica y la generación de nuevo conocimiento, sino que también promueven una conciencia crítica sobre la importancia de conservar los ecosistemas y las especies que los habitan.
La amplitud de estas colecciones —que abarcan desde microorganismos como bacterias y hongos hasta plantas y animales de distintos grupos taxonómicos— refleja la riqueza natural de Colombia y el compromiso institucional con su estudio y preservación. En conjunto, estos acervos contribuyen al desarrollo de jóvenes investigadores, fortalecen las capacidades científicas del país y sirven como una herramienta educativa y social para fomentar el uso sostenible y la protección de la biodiversidad colombiana.